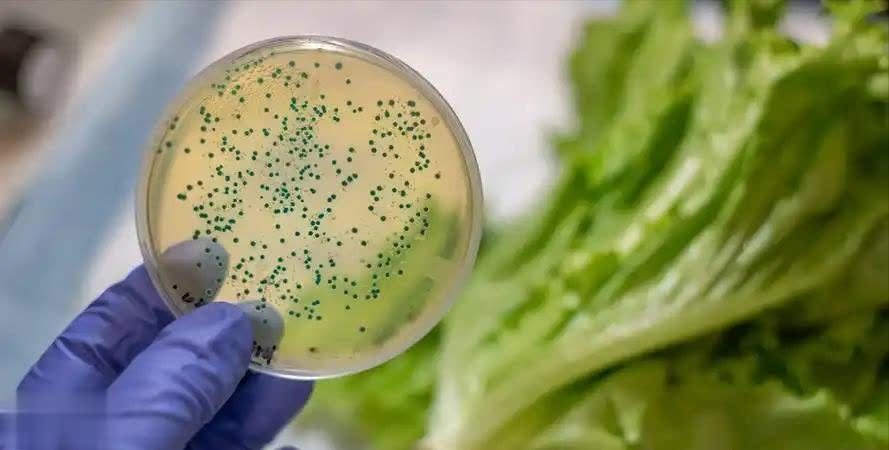

冰箱,这一日常生活中不可或缺的电器,扮演着举足轻重的角色,人们普遍倾向于将各类食品存放其中,认为这能延长保鲜时间。
然而,事实是,许多食品一旦进入冰箱环境,反而可能变得更加有害,甚至直接对身体健康构成威胁。
作为一名医生,我接触到过很多因为“冰箱食物”带来的健康问题的患者。
 冰箱里刚拿出来的过凉食物
冰箱里刚拿出来的过凉食物有一位年轻人刚刚大学毕业,工作压力大,生活作息也不规律,每天三餐总是匆匆忙忙,常常是在晚上从冰箱里拿出一些准备好的外卖或剩饭,快速加热后就狼吞虎咽地吃下去。
尤其是一些冷却后的食物,人们常常简单地将它们放入微波炉快速加热一下,出于便捷考虑,而忽略了食物是否已变凉、质地变硬的问题。

然而,经过一段时间,他开始出现了频繁的胃痛、腹胀、恶心等消化不良症状。经检查,发现他的胃黏膜受到显著刺激,已初步呈现出慢性胃炎的迹象。
我告诉他,正是因为他经常吃那些从冰箱里拿出来已经降温甚至过凉的食物,导致胃肠消化功能的负担加重,才引发了这些问题。

食物在冰箱里长时间存放后,它的温度和营养成分发生了变化,虽然加热后看起来像是“恢复了正常”,但是冷藏过程中食物的微生物种群发生了变动,其中一些有害细菌如大肠杆菌、沙门氏菌等在低温下也不会立刻死亡。
如果加热后没有完全彻底,食物中的细菌可能没有被完全消灭,再进入胃肠道后,就会引发不适,特别是胃肠系统脆弱的人,容易受到刺激,导致消化不良或胃肠炎。
 生熟食混放
生熟食混放在我曾经处理过的一个病例中,一位中年女性,长时间没有重视食物的存储和保鲜方式。
她习惯性地将生肉、熟食一起放入冰箱,有时候甚至没有用独立的盒子,而是直接随便放在一起。
她有一个嗜好,就是每次做完饭后,不太管冰箱里的食物是否接触到其他食材,经常混合存放。

几个月前,她出现了严重的腹痛和食欲不振,经过一系列检查后发现,她患上了细菌性食物中毒。
深入探究她的饮食习惯后,才意识到她频繁地将生肉与熟食混放,从而造成了大肠杆菌等有害菌的交叉污染。
尤其是生肉表面的一些微生物,虽然冷藏时它们的活跃性大大减缓,但如果与熟食接触,仍然能够在不当的加热环境下繁殖,进而引发食物中毒。

实际上,很多人并不清楚,生食和熟食混合存放,是一个非常严重的健康隐患。
生肉、鱼类等食材在处理过程中,含有大量的细菌和微生物,而这些细菌如果没有通过高温杀灭,可能在冰箱低温环境下仍然存活。
若熟食未能在同一空间内做到完全密封,其表面便容易遭受来自生食所携带细菌的侵袭与污染。

根据美国疾病控制和预防中心(CDC)的研究,食物中毒病例中,有很大一部分就是由于生熟食交叉污染造成的。
因此,专家强烈建议,所有食材都要严格区分存放,尤其是生食和熟食,最好分开保鲜,以减少交叉污染的风险。
腐烂的叶菜类
腐烂的叶菜类有时候,我们看到一些绿色蔬菜,比如菠菜、生菜等,放进冰箱后,虽然它们的外观依旧保持新鲜,但往往过了几天后,蔬菜的表面就开始发黄、发黑,甚至出现了霉斑。
我有一个患者就是因为长期食用这些“过期”的蔬菜而患上了严重的食物中毒症状。

这个患者是一位爱吃蔬菜的人,每天都会吃大量的沙拉或者做蔬菜汤,由于工作繁忙,常常提前准备好蔬菜,然后放进冰箱冷藏。
每次他看到冰箱里的叶菜有些枯萎或者稍微有点发黑,他就会认为那是正常现象,直接切掉霉变部分,剩下的继续食用。
长此以往,他开始出现了剧烈的腹泻、呕吐等症状。

经过详细检查后,医生发现他体内的黄曲霉毒素含量极高。原来,叶菜类蔬菜在长时间存放后,特别是出现霉斑时,很容易产生黄曲霉毒素。
此毒素对人体肝脏具有高度的毒性作用,长期摄入含有此类毒素的食品,会提升罹患肝脏疾病的风险,严重者甚至可能诱发癌症。
虽然冰箱能够暂时延缓蔬菜的腐败速度,但它并不能完全阻止霉菌的生长,如果蔬菜在存放过程中已经出现霉变,就算冷藏,它仍然无法保持完全的安全。
食品安全专家指出,蔬菜变黑、变软,已经不再是食物新鲜的标志。遇到这些情况,应该果断丢弃,而不是为了节约或者省事而食用。
 变黑的香蕉
变黑的香蕉香蕉,这一我们日常喜爱的水果,在放入冰箱后,其果皮上出现的黑色斑点,其实并非仅仅由于低温所致。前段时间,我接诊了一位常年食用变黑香蕉的患者。
他是个水果爱好者,他每天都会吃一根香蕉,有时候他觉得香蕉不够甜,于是就会把它们放到冰箱里,几天后,他发现这些香蕉变黑了,但他依然吃了下去。

他表示,吃了黑了的香蕉后,胃口一直不太好,吃完之后常常出现恶心和腹痛的症状。经过检查,发现他体内出现了过量的果糖,并且他的胃肠道对高浓度的果酸也有些不耐受。
原来,当香蕉进入冰箱后,低温促使香蕉中的糖分和果酸发生了恶性反应,这样的香蕉虽然看起来没问题,但其实它们的营养成分已经发生了变化,甚至可能引起肠胃的不适。

根据科学研究,低温环境下,香蕉中的淀粉会被转化为糖分,而这些糖分在过长时间的储存下会被大量释放,并且果酸的浓度也会增加。
这种变化对于一些肠胃比较敏感的人来说,尤其容易造成消化问题,研究显示,过度的糖分和果酸摄入,会增加胃肠道的负担,长期食用这样的香蕉,对健康极为不利。
这四种看似普通的食物,其实在冰箱中存放不当后,可能带来严重的健康隐患。

你是否也常常将这些食物放进冰箱,觉得它们能保持新鲜?如果你还在食用这些经过冰箱“变味”的食物,那么你要小心了。吃得不对,健康就会受到威胁。
以上内容仅供参考,若身体不适,请及时咨询专业医生
关于健康饮食您有什么看法?欢迎评论区一起讨论!
参考资料:[1]李瑞鑫,聂宇,蒋倩,等.社区慢性病老人健康素养现状调查及影响因素研究[J].卫生职业教育,2025.

金控配资提示:文章来自网络,不代表本站观点。